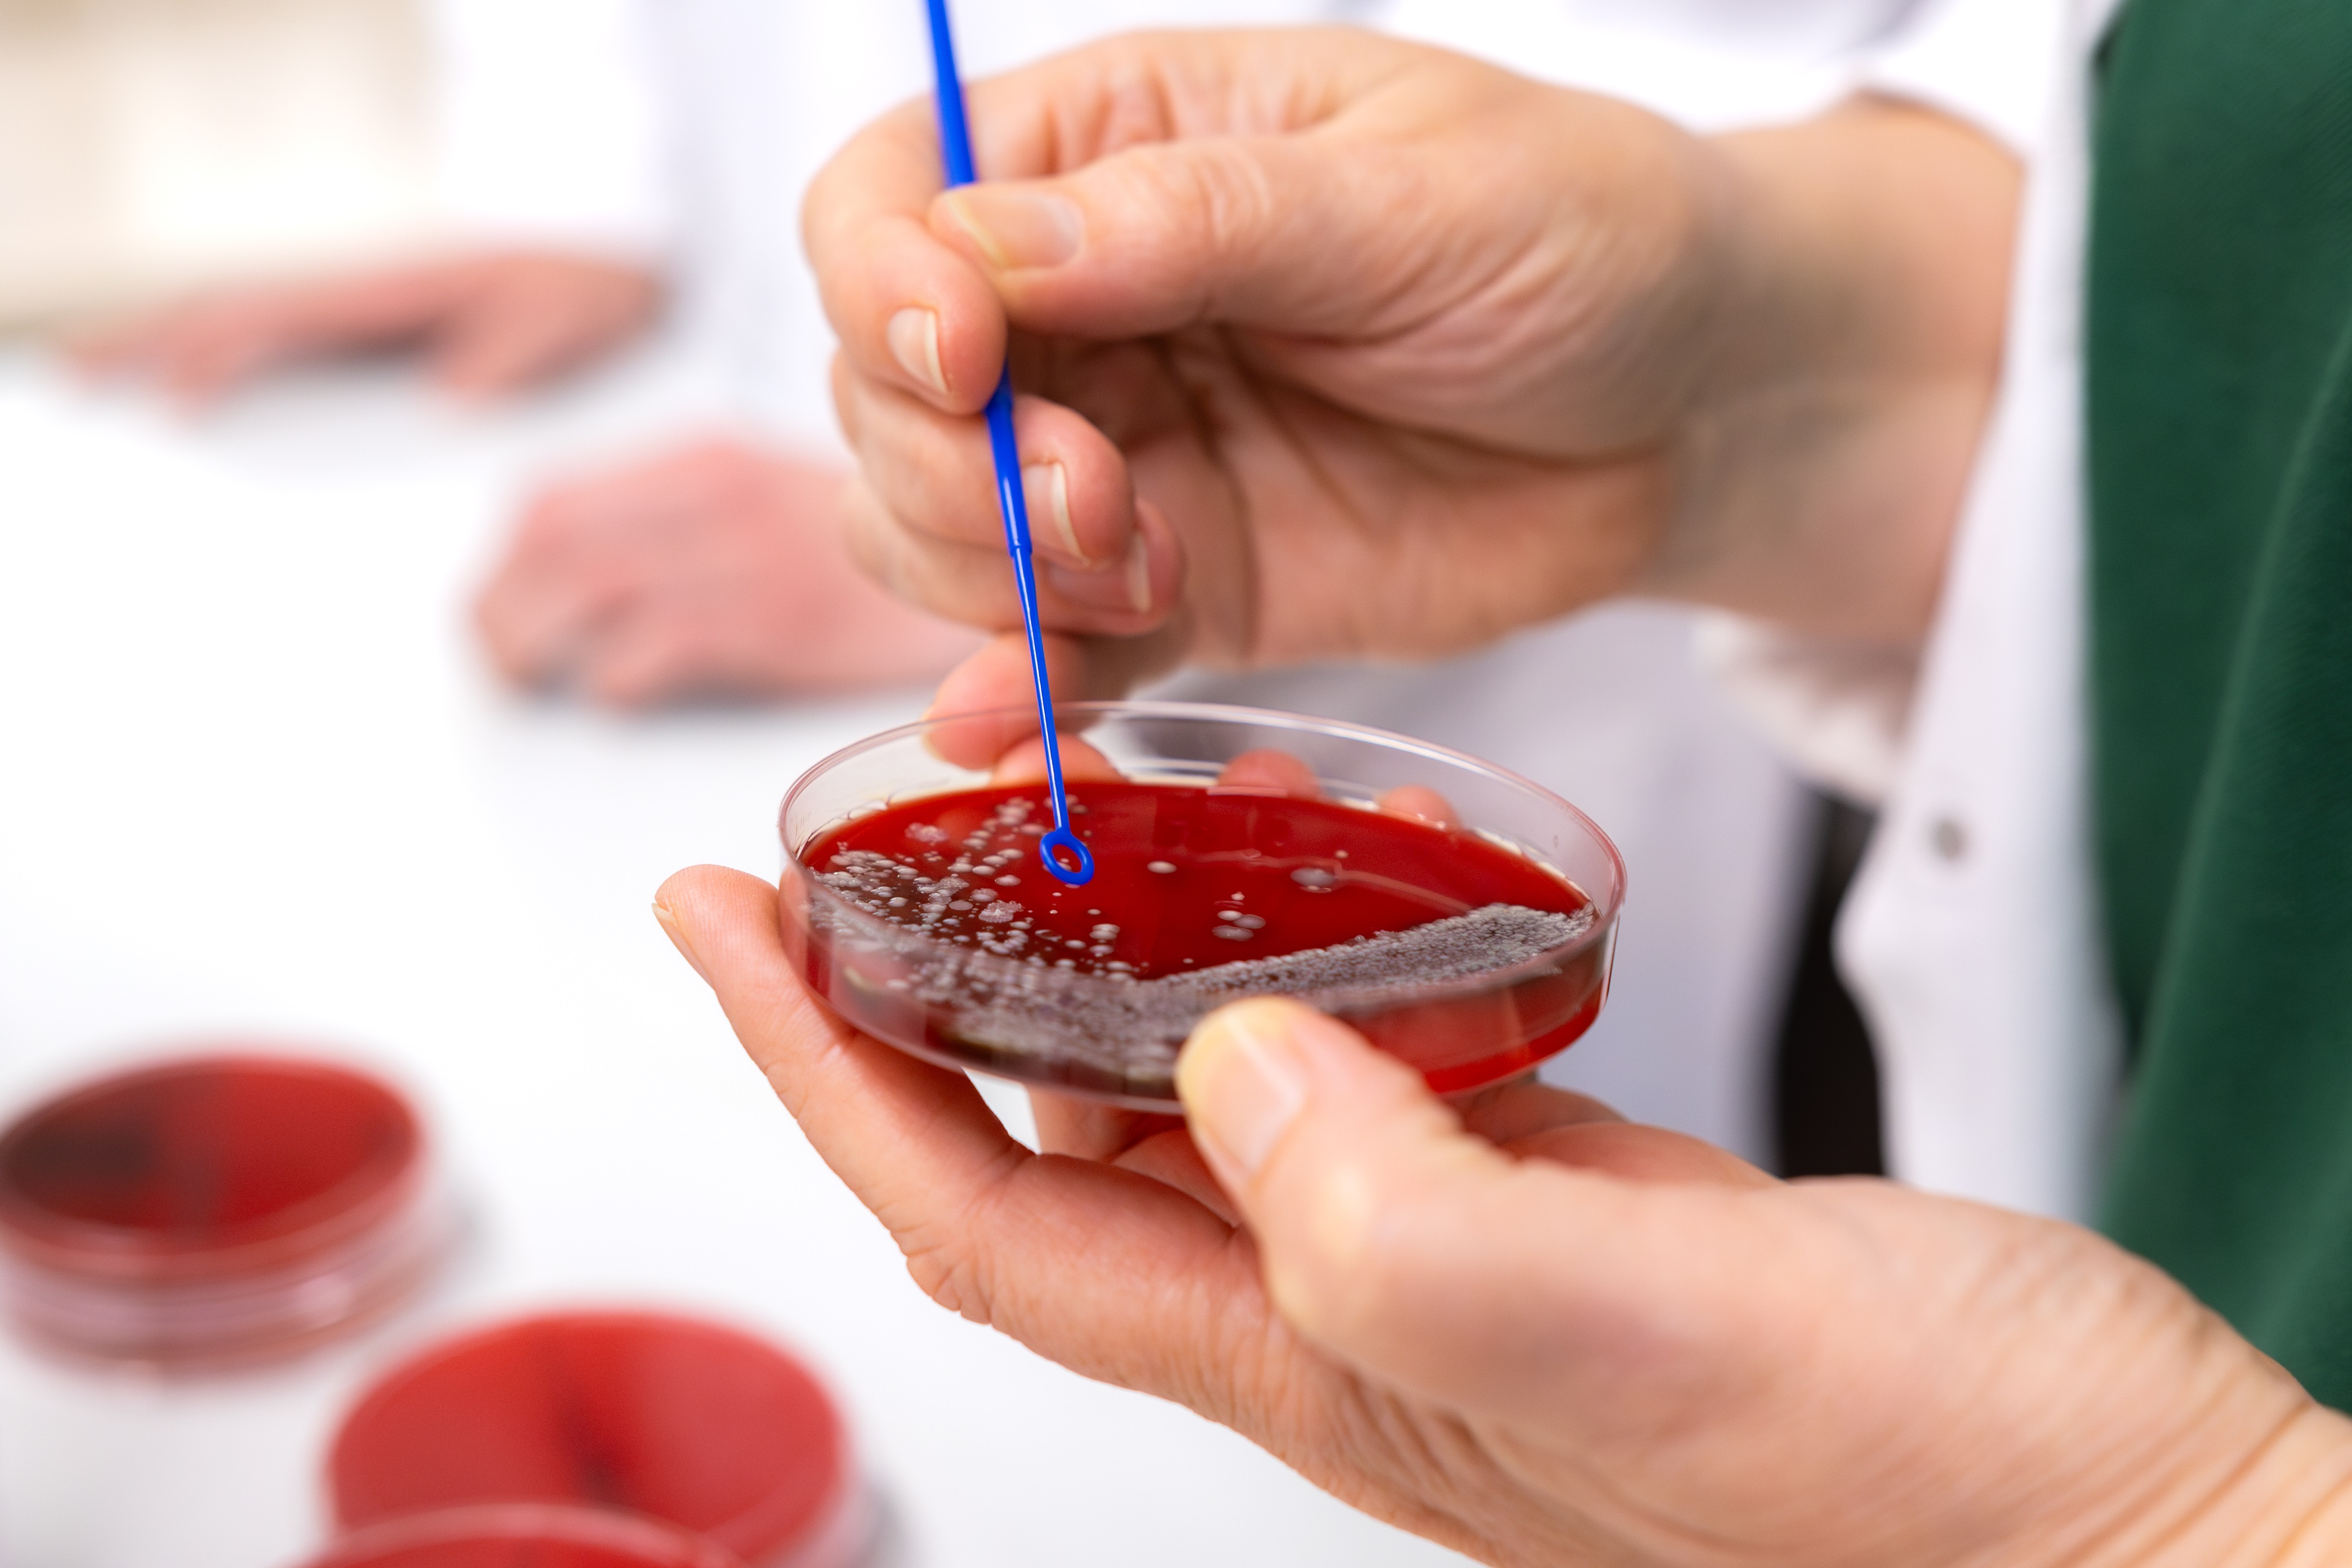

Deine Tierärzte für Nutztiere in Mühlen
Entdecke bei uns fortschrittliche Lösungen und ein Team, das sich leidenschaftlich für das Wohl deiner Tiere einsetzt.
Kontaktiere uns noch heute und erfahre, wie wir dich unterstützen können.
Wir stehen dir mit Rat und Tat zur Seite.
.jpg)
Unsere Leistungen
Schweine-
bestandsbetreuung
Von der Ferkelerzeugung bis zur Mast – wir unterstützen dich umfassend mit modernster Diagnostik und maßgeschneiderten Prophylaxekonzepten, um die Gesundheit deiner Tiere sicherzustellen.
Milchvieh-
bestandsbetreuung
Deine Milchviehherden verdienen die beste Betreuung. Unsere Experten bieten dir regelmäßige Besuche und detaillierte Beratung, um die Produktivität und Gesundheit deiner Kühe zu maximieren – von der Trächtigkeitsuntersuchung bis zum Zyklusmanagement.
Kälber- und Rinderbetreuung
Damit deine Kälber und Rinder optimal laufen: Wir bieten dir individuelle Lösungen zur Krankheitsprävention und -behandlung, optimierte Fütterung und gezielte Gesundheitsprogramme, um die Qualität und das Wachstum deiner Bestände zu fördern.
Labor-
untersuchungen
Unser Labor sorgt für schnelle und genaue Ergebnisse, indem wir verschiedene Methoden anwenden: Von der bakteriologischen Untersuchung (BU) von Proben, über die Parasitologie bis hin zu molekularbiologischen und serologischen Tests für viele Bakterien und Viren. Eine zeitnahe und effektive Behandlung deiner Tiere wird damit sichergestellt.
Aktuelle Stellenangebote
Werde Teil unseres Teams und gestalte die Zukunft der Tiermedizin mit.
.webp)
Dein Partner für Tiergesundheit
Seit 1980 ist die Tierarztpraxis Dr. B. Kiene & Kollegen dein verlässlicher Partner für die Gesundheit deiner Nutztiere. Unser erfahrenes Team steht dir mit umfassender Betreuung und modernster Diagnostik zur Seite.
Unsere Praxis hat sich von einer Einzelpraxis zu einer spezialisierten Einrichtung entwickelt, die sich auf Aufzucht-, Vermehrungs- und Mastbetriebe im Rinder- und Schweinebereich konzentriert. Mit einem eigenen Labor, einer Apotheke und eigener cloudbasierter Softwarelösung bieten wir dir schnelle und präzise Diagnostik sowie maßgeschneiderte Behandlungskonzepte.
Wir legen großen Wert auf kontinuierliche Weiterbildung und die Anwendung modernster Methoden, um den hohen Anforderungen der heutigen Landwirtschaft gerecht zu werden.
Unsere langjährige Erfahrung und unser Engagement für Tiergesundheit und Wohlbefinden in Nordwestdeutschland machen uns zu einem wertvollen Partner für deinen Betrieb.
Fortbildungen und Veranstaltungen
Unsere Events bieten dir die Möglichkeit, auf dem neuesten Stand der Tiermedizin zu bleiben und dich mit Gleichgesinnten auszutauschen.
Wir freuen uns darauf, dich dort zu sehen und gemeinsam neue Erkenntnisse zu gewinnen!
Du möchtest auch Partner werden?
Kontaktiere uns, um mehr über die Möglichkeiten einer Partnerschaft zu erfahren. Wir freuen uns darauf, von dir zu hören
Hast du noch Fragen?
Schreibe uns einfach oder erreiche uns telefonisch unter 05492 970 100. Wir helfen dir gerne weiter und freuen uns, dir zur Seite zu stehen.
Unser Büro ist von Montag - Freitag von 7:30 - 17:00 Uhr erreichbar.

%20(1)%20(1).avif)











